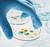

![]()




A program update built from direct teacher and student feedback across the U.S.
All new features help students advance real-world communication skills and give teachers clear, actionable pathways.
Essential functions, routines, and new practice activities that build confidence from day one and prepare students for the core units.
Vocabulary activities at the end of every lesson.
Authentic, fresh, relevant references, visuals, places, and personalities.
ALL LEVELS
Inspired by Reporteros 4 and now extended across the entire Revised Edition.
Alternative exam versions, proficiency-based assessment, and more performance opportunities.
Launch-ready lesson plans, expanded teaching notes, and clearer instructional sequencing.

Redesigned with front matter, explicit mode tagging, pacing help, and integration of all supplements.
The Reporteros Readers and the CTE, ADI, and GenAI Companions are now better integrated into the program.




Personalized interpersonal conversations directly connected to each unit.

New UX/UI, cleaner navigation, improved assignments, and a brand-new skills report.



The KWL Hub brings together all student and teacher resources in one streamlined platform. With interactive tools, multimedia content, assignments, progress tracking, and full LEO integration, it simplifies instruction and supports learning anytime, anywhere.
A media-rich digital version of the Student Edition and Workbook with audio, video, and cultural notes at point of use.
A fully interactive HTML experience where students can:
• write in text fields
• record audio
• upload files
• check answers
• complete auto-graded & teacher-graded tasks
• track their progress




Quick grammar and vocabulary checks tied to lesson content.
Short, targeted videos for grammar, pronunciation, and spelling.
• My Progress worksheets
• Assessment rubrics
• Self/peer assessment tools
• Spanish–English glossaries
• Maps & cultural references …and more.






Accessible on any device—phone, tablet, laptop, or desktop—through browser or app. Teachers can assign work, review results, monitor LEO transcripts, and integrate the Hub with their LMS in a few clicks.
The KWL Hub offers multiple digital tiers, allowing schools and districts to choose the level of interactivity and tools that best fit their instructional goals and financial plans—from essential access to fully interactive, AI-enhanced experiences.
Contact your Klett World Languages representative to discuss the options that best fit your district.
klettwl.com/find-your-rep
MINIPROYECTO 2


GRAMMAR AND COMMUNICATION


VOCABULARY AND PRONUNCIATION


• basic greetings and daily expressions
• useful expressions in the class
MINIPROYECTO 1
Create a poster for a Latino/a personality.
MINIPROYECTO 2
Create a class album.
PROYECTO FINAL
Interview personalities for a talk show.
LECCIÓN 1
• subject pronouns
• the verbs ser, tener and llamarse
• definite articles
• question words
• gender and number of nouns
LECCIÓN 2
• regular -ar, -er and -ir verbs
• adjectives of nationality
• indefinite articles
• expressing cause
LECCIÓN 1
• countries
• dates: days of the week, months and numbers from 1 to 31
• seasons and weather
• classroom objects
• Spanish alphabet and sounds
• numbers from 0 to 100
• basic personal information
• greetings
• occupations
• the letter H
LECCIÓN 2
• nationalities and origin
• languages
• places where we live
• facts about the Spanish language
• geography of the Spanish-speaking world
• some traditions and celebrations in the Spanish-speaking world
• vowels 2 1
LECCIÓN 1
• Mexican Americans
• famous Spanish-speaking people
• Día de Muertos
• Hispanic Heritage Month
LECCIÓN 2
• the multiculturalism of the Spanish-speaking world
• differences between hispano/a and latino/a
MINIPROYECTO 1
Create their profile for an online platform.
MINIPROYECTO 2
Introduce the important people in their life.
PROYECTO FINAL
Participate in a special edition of the school magazine.
LECCIÓN 1
• the verb gustar
• también / tampoco
• quantifiers: muy mucho
• noun-adjective agreement
LECCIÓN 2
• possessive adjectives
• possession with de
LECCIÓN 1
• activities
• music
• animals and pets
• personality traits
• stressed syllables
LECCIÓN 2
• family relationships
• physical traits
• parts of the body
• accent marks
LECCIÓN 1
• sports, music and animals in Puerto Rico
• La Borinqueña, a Puerto Rican superheroine
• the Taino culture
LECCIÓN 2
• family names in Spanishspeaking countries
• some Puerto Rican artists
• Arturo Schomburg, a Puerto Rican historian and activist
Un colegio para todo el mundo Una semana conmigo Hogar, dulce hogar
MINIPROYECTO 1
Design the perfect house for a family.
MINIPROYECTO 2
Create a campaign for dividing up chores.
PROYECTO FINAL
Present a sitcom project about a family.
LECCIÓN 1
• expressing existence with hay
• the verb estar to locate
• prepositions of place
LECCIÓN 2
• ser and estar
• tener que + infinitive
• adverbs of frequency
• irregular yo form in the present: poner and hacer
LECCIÓN 1
• parts of a house
• furniture
• decoration
• colors and materials
• the soft R
LECCIÓN 2
• describing a space
• household chores
• the hard R
MINIPROYECTO 1
Create an informational brochure about their ideal school.
MINIPROYECTO 2
Create a poster and video for a candidate as part of their campaign.
PROYECTO FINAL
Create a video presentation of their school.
LECCIÓN 1
• telling time
• stem-changing verbs: empezar and poder
LECCIÓN 2
• the verb estar to describe feelings and moods
• comparatives
• superlatives
LECCIÓN 1
• areas of a school
• school subjects
• clothes
• the letter Ñ
LECCIÓN 2
• feelings and moods
• school elections and school life
• qualities and personality traits
MINIPROYECTO 1
Create a vlog about their daily routine.
MINIPROYECTO 2
Create a comic strip about their free time.
PROYECTO FINAL
Present about a summer camp for young people.
LECCIÓN 1
• reflexive verbs
• stem-changing verbs: vestirse and jugar
• the verb ir
LECCIÓN 2
• the present progressive: estar + present participle
• direct object pronouns
• ir a + infinitive
LECCIÓN 1
• routine
• meals
• sports
• linking words
• the sound of S, CE, CI and Z
LECCIÓN 2
• leisure activities
• statistics
• electronic devices
• hiatus 3 6 5 4
LECCIÓN 1
• traditional Mexican homes
• Mexican style décor
• Two Mexican architects
• Frida Kahlo’s Casa Azul
LECCIÓN 2
• Carmen Lomas Garza,
a Chicano artist
• Photography project: bedrooms around the world
• the sound of J, GE and GI
LECCIÓN 1
• the Colombian education system
• the writer Yolanda Reyes
• a Colombian education project promoted by Shakira
LECCIÓN 2
• schedules, holidays, and homework
• Colombian Teachers’ Day
• a Colombian positivity school campaign
• the sound of B and V
LECCIÓN 1
• schedules in Spain
• flamenco music
• sports in Spain and other Spanish-speaking countries
• FC Barcelona Sports Academy
LECCIÓN 2
• hobbies and eSports in Spain
• famous squares in Madrid
• a young adult fiction writer: Laura Gallego
Un país con gusto y estilo
MINIPROYECTO 1
Act out a scene in a secondhand market.
MINIPROYECTO 2
Create a Peruvian cuisine food truck project.
PROYECTO FINAL
Create a survival guide for tourists in Peru.
LECCIÓN 1
• demonstrative adjectives and pronouns
• question words
• indirect object pronouns
• interact in a store
LECCIÓN 2
• adjectives of quantity + nouns
• past tense: the preterite
LECCIÓN 1
• clothes, accessories and styles
• stores
• numbers from 100 to 1000
• interact in a restaurant
• diphthongs
LECCIÓN 2
• food and eating habits
• dishes and cooking techniques
• vocabulary in a restaurant
LECCIÓN 1
• the city of Lima
• Peruvian textiles
• Peruvian fashion bloggers
• Meche Correa, a Peruvian designer
LECCIÓN 2
• Peruvian food and drinks
• Peruvian superfoods
• Peruvian cuisine as a fusion of cultures

GRAMMAR AND COMMUNICATION

VOCABULARY AND PRONUNCIATION


• the verbs hay, ser, tener, gustar, estar, and ir
• indefinite articles
• noun-adjective agreement
• the present tense: regular, reflexive, and stem-changing verbs
• possessive adjectives
• verbs with irregular yo forms
• ir a + infinitive
• classroom objects
• occupations
• nationalities
• numbers
• clothes
• daily routines
• family relationships
• feelings and moods
• leisure activities
• the letter R 2 1 0
• people, places, and cultural practices and products of the Spanish-speaking world
MINIPROYECTO 1
Create a video about a neighborhood to welcome new neighbors.
MINIPROYECTO 2
Create a poster featuring school rules.
PROYECTO FINAL
Create a digital information guide about a neighborhood.
LECCIÓN 1
• ser, hay, and estar
• irregular verbs: salir and venir
• pronouns after prepositions
• locating places
• making plans
LECCIÓN 2
• hay que + infinitive
• impersonal se
• direct object pronouns
• indirect object pronouns
LECCIÓN 1
• the city
• describing and locating places
• means of transportation
• plans
• the sound of -CIÓN and -CCIÓN
LECCIÓN 2
• community life
• city rules
• recycling
LECCIÓN 1
• neighborhoods in Madrid
• markets in Spain
• iconic sites in Madrid
• European Mobility Week
• leisure activities in Madrid
LECCIÓN 2
• local business in Spain
• the 24-hour time system
• recycling in Spain
• resident and volunteer associations
MINIPROYECTO 1
Have a Argentinian trivia contest.
MINIPROYECTO 2
Create a collaborative travel journal.
PROYECTO FINAL
Create a sustainable tourism route in Argentina.
LECCIÓN 1
• conocer and saber
• relative and absolute superlatives
• expressing preferences
LECCIÓN 2
• the preterite: regular, stem-changing, and some irregular verbs
• ordinal numbers
LECCIÓN 1
• geography, experiences, and trips
• weather, seasons, and cardinal directions
• the sound of LL and Y
LECCIÓN 2
• tourist activities, means of transportation, and lodging
• adjectives to describe experiences
• stressed syllables
LECCIÓN 1
• tourist attractions in Argentina
• the Celsius scale
• the southern hemisphere
• asado and mate
• responsible tourism
LECCIÓN 2
• the cartoonist Liniers
• el Tren a las Nubes
• la Ruta Nacional 40
• the writer Aniko Villalba
• the Zapp family
Historias de ayer y de hoy
MINIPROYECTO 1
Create a presentation that compares the childhoods of two generations.
MINIPROYECTO 2
Create a video about an object that has history.
PROYECTO FINAL
Participate in a short story contest.
LECCIÓN 1
• the imperfect tense
• comparatives
• affirmative and negative words
LECCIÓN 2
• hace / desde / desde hace
• direct and indirect object pronouns combined
• irregular preterite verbs
• preterite vs. imperfect tense
• conversational reactions
LECCIÓN 1
• toys and games
• education
• means of communication
• cities
• time expressions
• spelling rules for J and GE, GI
LECCIÓN 2
• numbers from 1,000 to 100,000
• biographies
• time expressions
• accent mark rules
LECCIÓN 1
• Chilean education
• landmarks in Santiago
• streetcars in Santiago
• the Mapuche
LECCIÓN 2
• a famous Chilean television series
• Condorito, a comic character
• the poet Gabriela Mistral
• the diaries of a girl who wrote about Pinochet’s coup d’état
MINIPROYECTO 1
Create a poster to promote teenagers’ well-being.
MINIPROYECTO 2
Act out an interview with an athlete for a podcast.
PROYECTO FINAL
Create a campaign about physical and emotional health and healthy habits.
LECCIÓN 1
• affirmative and negative informal commands
• informal commands with pronouns
LECCIÓN 2
• recommendations with ser + adjective and deber
• the verb doler
LECCIÓN 1
• feelings and moods
• relationships
• spelling rules for C, QU, and K
LECCIÓN 2
• health
• body parts
• useful phrases at the doctor’s office
• spelling rules for G, GU, and GÜ
LECCIÓN 1
• the pura vida attitude
• the origin of the name tico/a
• Costa Rica’s wellness campaigns
• what makes Costa Rica
a happy place
LECCIÓN 2
• Costa Rican fruits
• accomplished Costa Rican athletes
• the dengue virus
• the para surfer Jimena Ruiz
Un futuro prometedor
3 6 5 4
MINIPROYECTO 1
Create a poster celebrating Earth Day.
MINIPROYECTO 2
Create a mind map of their life project.
PROYECTO FINAL
Write a special edition of the school magazine about the future.
LECCIÓN 1
• the future tense
• por and para
• si clauses in the present and future tenses
LECCIÓN 2
• reflexive verbs
• adverbs ending in -mente
• the conditional tense
• making hypothesis, giving advice, and expressing wishes
LECCIÓN 1
• changes
• technology, food, and society
• the environment
• the sounds of D and T
LECCIÓN 2
• occupations
• personality traits
• skills and job requirements
• time expressions
• the sounds of B / V, and P
LECCIÓN 1
• biodiversity in Ecuador
• Andean catzo
• the Ecuadorian regions of Galapagos and Amazonia
LECCIÓN 2
• a vocational camp in Ecuador
• summer activities in Ecuador
• Ecuadorian women pioneers in their jobs
El gusto de celebrar
MINIPROYECTO 1
Audition for a Mexican cooking show.
MINIPROYECTO 2
Present a national celebration that is special to them.
PROYECTO FINAL
Prepare an exhibit about Mexican celebrations and traditions.
LECCIÓN 1
• the impersonal se
• usted and ustedes commands
• giving instructions
LECCIÓN 2
• expressing habitual actions with ser + adjective and soler
• si clauses + commands
• preterite vs. imperfect tense
LECCIÓN 1
• food
• meals and eating habits
• tastes
• cooking
• linking sounds
LECCIÓN 2
• celebrations
• social habits
• clothing and styles
• time expressions
• capital and lowercase letters
LECCIÓN 1
• Diego Rivera
• Mexican Fiestas Patrias
• corn and chili peppers in Mexico
• the origin of chocolate
• Mesoamerican civilizations
LECCIÓN 2
• the Veracruz Carnival
• la Guelaguetza
• la Quinceañera
• los Voladores de Papantla
• el Cinco de Mayo
GRAMMAR AND COMMUNICATION


interesa… no creo…
• the present tense
• affirmative and negative tú commands
• the impersonal se
• habitual actions with
es + adjective and soler
• the verbs hay, ser, and estar
• the preterite tense
• the imperfect tense
VOCABULARY


• health-related issues
• feelings and moods
• food and celebrations
• cities
• travel experiences
• biographies
• communication
• describing houses
• people, places, cultural practices, and products of the Spanish-speaking world
MINIPROYECTO 1
Present a collage about themselves.
MINIPROYECTO 2
Record a podcast about anecdotes with friends.
PROYECTO FINAL
Create and act out a scene from a web series.
LECCIÓN 1
• the verbs ser and parecer + adjective
• the verbs interesar importar and preocupar
LECCIÓN 2
• reflexive constructions to express reciprocity
• the past progressive
• the preterite tense vs. the imperfect tense
LECCIÓN 1
• personality traits, moods, changes and social issues
• expressing opinions, agreement, and disagreement
LECCIÓN 2
• personality traits, feelings, and relationships
• asking for advice and making recommendations
• linking words
LECCIÓN 1
• young people in Mexico
• three young Mexican artists: Girl Ultra, Diego Boneta, and Ángela Aguilar
LECCIÓN 2
• the three amigos: Alejandro Iñárritu, Guillermo del Toro, and Alfonso Cuarón
MINIPROYECTO 1
Create a brochure for exchange students.
MINIPROYECTO 2
Interview an immigrant or descendant of immigrants.
PROYECTO FINAL
Play a board game about traveling.
LECCIÓN 1
• the present perfect tense
• adjective clauses
LECCIÓN 2
• the past perfect tense
• acabar de / dejar de / empezar a / volver a + infinitive
• pasar tiempo + present participle
LECCIÓN 1
• travel activities
• trips and travel experiences
• clothing and luggage
• volunteering
LECCIÓN 2
• immigration and stereotypes
• belonging
• cultural heritage
• describing experiences
• time expressions
LECCIÓN 1
• the Panama Canal
• the Baru volcano
• the Panama Canal’s famous train
LECCIÓN 2
• Isaac Villaverde, an Afropanamanian chef
• the history of Panama
• the Chinese community in Panama
MINIPROYECTO 1
Rank the five most valued applications by the class.
MINIPROYECTO 2
Create a digital citizenship test.
PROYECTO FINAL
Participate in a debate about how we show ourselves on social media.
MINIPROYECTO 1
Create their video resume.
MINIPROYECTO 2
Do a job interview.
PROYECTO FINAL
Participate in an activity fair.
• art 3 6 5 4
LECCIÓN 1
• the present subjunctive: regular and irregular verbs
• para and para que
• gustar / molestar que + present subjunctive
LECCIÓN 2
• the present subjunctive: more irregular verbs
• impersonal constructions
• es cierto que + indicative, no es cierto que + subjunctive
LECCIÓN 1
• technology and social media
• feelings
• activities on the internet
• linking words
LECCIÓN 2
• digital responsibility and technology
• news
• written messages
• useful phrases for writing an emails
LECCIÓN 1
• Uruguayan technology programs and assistive technologies in schools
LECCIÓN 2
• a pact against misinformation
Uruguay
• Jorge Drexler, an Uruguayan artist
• literary influencers in Uruguay
LECCIÓN 1
• expressing skills: costar, resultar fácil / difícil
• the future tense
• cuando + present subjunctive
• saber and poder
LECCIÓN 2
• expressing wishes and hopes: esperar / desear / ojalá / … + que + present subjunctive
• adjective clauses with the present subjunctive
LECCIÓN 1
• abilities and skills
• studies
• careers and career paths
LECCIÓN 2
• world of work
• useful phrases for a cover letter and a job interview
• useful phrases for a job interview
LECCIÓN 1
• Miguel Rojas, a Venezuelan passionate of astronomy
• el Sistema Nacional de Orquestas y Coros Juveniles e Infantiles de Venezuela
LECCIÓN 2
• a book by Antonio Skármeta, a Chilenean writer
• Yulimar Rojas and Gleyber Torres, two Venezuelan athletes
MINIPROYECTO 1
Create a program of activities for Biodiversity Day.
MINIPROYECTO 2
Write a petition for their community in an open letter.
PROYECTO FINAL
Present an interactive map with projects to improve the environment.
LECCIÓN 1
• lo + adjective
• lo que + verb
• the conditional tense
LECCIÓN 2
• past participles as adjectives
• pedir / necesitar / lograr / permitir / … + que + present subjunctive
LECCIÓN 1
• wild animals
• the environment and our relationship with it
• eating habits
• linking words
LECCIÓN 2
• environment and sustainability
• clothing industry
• requests
• useful phrases for writing a formal letter
LECCIÓN 1
• Bolivia’s environmental diversity
• the Andean philosophy of el buen vivir
• el Salar de Uyuni
LECCIÓN 2
• Salvé, a Bolivian sustainable clothing brand
• atrapanieblas, a Latin American environmental technology
MINIPROYECTO 1
Create an album of visual book reviews for a library.
MINIPROYECTO 2
Write a story starting from a picture.
PROYECTO FINAL
Participate in a public reading of books in Spanish.
LECCIÓN 1
• the imperfect subjunctive
• si clauses: imperfect subjunctive + conditional
• recomendar que + subjunctive
LECCIÓN 2
• making hypothesis: quizá puede ser que + subjunctive
• the preterite, imperfect, past progressive, and past perfect tenses
LECCIÓN 1
• literary and film genres
• reviews
• recommendations and opinions
• summarizing a plot
LECCIÓN 2
• stories and legends
• describing characters and images
LECCIÓN 1
• Spanish TV series El Ministerio del Tiempo
• Spanish writers: Carmen Martín Gaite, Carlos Ruiz Zafón, Paco Roca…
LECCIÓN 2
• the character Don Quijote
• Diego Velázquez’s painting Las Meninas
• Sant Jordi a Catalan celebration

GRAMMAR AND COMMUNICATION

si fueras… habría ido… en definitiva, …
What impact does our lifestyle have on our emotions, our communities, and our environment?
PROYECTO FINAL
Create a promotional video to encourage new members to participate in a local organization.
How can languages foster connections and communication across communities?
What role can AI play in language learning and education?
PROYECTO FINAL
Present a program of activities designed to highlight a minority language and encourage its recognition and study.
• past participles as adjectives
• the present tense
• the preterite tense vs. the imperfect tense
• expressing wishes and effects: querer / hacer + infinitive; querer que / hacer que + the present subjunctive
• concessive clauses: no importar + noun + que + the present subjunctive
• question words
• the future tense
VOCABULARY


• graphs and economy,
• lifestyles, fashion, and music
• emotions, identities, communities, and values
• greetings in informal conversations and emails
• useful expressions for making plans, showing interest in a topic, and requesting more information
• useful expressions for writing an opinion piece
• word formation
• linking words
• alpaca fiber in Peru
• Annaïs Yucra and Marina Testino, two Peruvian fashion designers
• ImillaSkate, a group of young women skateboarders from Bolivia
• Los ríos profundos, a book by José María Arguedas, a Peruvian writer
• the National Natural Reserve of San Fernando in Peru
• Barranco, a neighborhood of Lima
• Machu Picchu, an Inca citadel in Peru
• cumbia in Peru and merengue in the Dominican Republic
• expressing wishes and effects in the past: querían + infinitive / querían que + the imperfect subjunctive
• expressing opinions: parecer bien / mal (que) + infinitive / subjunctive
• uses of the present participle
• making hypothesis: es posible que + present subjunctive, quizá + indicative / subjunctive
• making suggestions
• impersonal constructions es + adjective + infinitive / es + adjective + que + present subjunctive
• communication, languages, multilingualism, language learning, and body language
• feelings, emotions, and accessibility
• artificial intelligence and education
• useful expressions for making arrangements for a meeting
• useful expressions for describing advantages and disadvantages, and giving examples
• useful expressions for comparing
• linking words
• indigenous language families in Latin America
• guaraní, a native language spoken in Paraguay and other countries of the region
• quechua, a native language spoken in Bolivia and other countries of South America
• the official sign language in Paraguay
• Rozalén, a Spanish pop-folk musician, and Beatriz Romero, a Spanish sign language interpreter
• body language for communication in Spanish-speaking countries and in the United States
3 6 5 4
How do scientific and technological innovations change environmental and health conditions?
PROYECTO FINAL
Create a podcast about technological and scientific innovations related to health and the environment.
What role does cultural heritage play in the economic and social development of a country?
PROYECTO FINAL
Create a brochure about lacrosse for Guatemalan students.
How are different forms of beauty embraced and celebrated within their cultures?
PROYECTO FINAL
Create an exhibit about Colombia with images, stories, and poems.
How does the Hispanic community influence the US?
PROYECTO FINAL
Write an issue of a magazine about influential Hispanic people in the United States.
• the passive voice (ser + participle) and the passive se
• uses of the conditional
• the future perfect tense
• possessive pronouns
• conditional clauses: en el caso de que / a menos que + subjunctive
• the imperfect subjunctive: irregular verbs
• si clauses: imperfect subjunctive + conditional
• science and technology
• environmental challenges, sea habitats, and conservationism
• health and health services
• agricultural practices
• time expressions
• useful expressions for summarizing information
• useful expressions for requesting favors, expressing conditions, and agreeing
• useful expressions for comparing
• linking words
• Bayahibe coral reef, Dominican Republic
• the Dominican Health System
• dengue, an endemic desease
• Julia Álvarez, American writer of Dominican origins
• coffee in the Dominican Republic
• cocoa in Colombia
• al + infinitive
• adjective clauses: el / cual, los / las cuales quien(es)
• conditional clauses: siempre que / siempre y cuando + subjunctive
• time clauses: al / antes de / después de + infinitive antes de que / después de que + imperfect subjunctive
• making hypothesis: a lo mejor / igual
+ indicative, puede que / es posible que + subjunctive
• the present perfect subjunctive: haber (present subjunctive) + past participle
• statistics, population, socioeconomics challenges, and forest resources
• biographies, immigration, and belonging
• traditional games and sports
• useful expressions for welcoming, thanking, and introducing someone giving instructions
• useful expressions for giving instructions
• useful expressions for oral presentations
• time expressions
• word formation: diminutives
• linking words
• demographic distribution in Guatemala
• xate, a native plant from Guatemala
• Luis von Ahn, a Guatemalan entrepreneur and computer scientist
• the origin of the name chapín / chapina
• las muñecas quitapenas, small, hand-made dolls from Guatemala
• Pok Ta Pok, the Mayan ball game
• the ancient Mayan civilization
• the ancient Inca civilization
• noun-adjective order
• commands
• expressing purpose: para + infinitive, para que + subjunctive
• estar + present participle
• estar + past participle
• time clauses: acabar de + infinitive, apenas / en el instante en que + conjugated verbs
• telling stories using past tense combinations
• describing events with ser
• art, architecture, literature, and cultural traditions
• describing people and places
• como / cómo
• stories, magical realism, and literary language
• useful expressions for describing events
• useful expressions for greeting, thanking, making proposals, and finishing a formal emails
• useful expressions for oral presentations
• Stefania Tejada, a Colombian artist
• orchid, the national flower of Colombia
• La tierra del olvido a song by Colombian song writer and singer
Carlos Vives
• Barranquilla’s carnival
• el realismo mágico
• Cien años de soledad, a book by Colombian Nobel laureate Gabriel García Márquez
• colonial architecture in Cartagena de Indias and New Orleans
• colonial and Creole architecture in New Orleans
• the past perfect subjunctive
• the conditional perfect tense
• si clauses: past perfect subjunctive, conditional perfect
• combining past tenses: preterite, imperfect, and past perfect
• reported speech
• making recommendations: recomendar + noun, recomendar que + subjunctive
• time clauses
• economy and professional world
• towns and communities
• biographies
• sports
• historical events
• achievements
• useful expressions to talk about events and experiences in various time frames
• useful expressions to make a presentation in an organized way and with some detail about the topic presented
• the Hispanic community of New Braunfels, Texas
• five Hispanic people in the world of space science. Noelia González, Frank Rubio, Rosa Avalos-Warren, Katya Echazarreta, and Ellen Ochoa
• Los reyes del mambo tocan canciones de amor, a book by American writer Oscar Hijuelos
• Hispanic sportpeople in the US
• Latin music styles and salsa music in New York
• Tex-Mex and Guatemalan cuisine
Reporteros’ video
Each unit is built around a reportero/a, a teenager from a Spanishspeaking country. In the video, the reporteros introduce themselves, their country, and the main topics of the unit.
Miniproyectos and Proyecto final
The two Miniproyectos (one per lesson) and the Proyecto final (one per unit) are real-world projects in which you will use the grammar, vocabulary, and communicative skills you learned in each lesson.


Each unit contains two lessons. There is one introduction page for each.
Lesson objectives
A visual summary of the lesson objectives: the first column presents the communicational objectives, the second presents the vocabulary and grammar structures, and the third shows the cultural aspects of the lesson.



Information on the featured country or region
A map of the reporteros’ country with information, statistics, and interesting facts.
Opening activity
An activity based on the short text and the video about the reporteros’ country or region.
Cultura
A short text about a specific cultural element.
Reporteros’ chat
Text messages in which the six reporteros talk about the main topic of the unit and some basic vocabulary is introduced.
Four double-page spreads per lesson, each representing a different theme.










Materials and worksheets for activities: Differentiation, Heritage, Extra Material and the interactive Workbook.
Conexión
A short text describing cultural aspects that are related to other disciplines.
A magazine feature with articles written by different reporteros. Each one focuses on a relevant cultural topic from their home country and includes activities to help you explore it.




With these activities, students can make complex decisions and are able to frame, analyze, and synthesize information to solve problems and answer questions.
¡Eres reportero/a! You’ll become a reportero/a by creating a short journalistic report (written or recorded) as your contribution to the Somos reporteros magazine.
Various tips and strategies for successfully carrying out the ¡Eres reportero/a! activity.
Mi gramática
Grammar presentation
Visual, colorcoded explanations with diagrams, outlines, examples, and illustrations to help you internalize the grammatical structures of the lesson.

References to visually appealing Grammar tutorials and to Selfcheck Quizzes for practicing lesson structures.
Grammar activities
Practice activities for grammar structures. Stars show difficulty levels: from 1 (easiest) to 3 (most challenging).
Mi vocabulario
Vocabulary presentation
A clear, visual presentation: every word or phrase is illustrated and translated and the stressed vowel is always in bold.


Sonidos y Letras
A brief explanation followed by audio recordings for listening and repetition with practice activities, and video tutorials.
Palabras
Fun supplementary activities using the vocabulary covered in the lesson.


Communication tasks Real-life







Proyecto


Me preparo para la evaluación · IPA Activities designed to prepare for the Evaluación (IPA) of this unit. You will find complete IPA-like tasks that reflect the three modes of communication
INTERPRETIVE
INTERPRETIVE
INTERPRETIVE READING Read the text and answer the questions.
PEPITO , UN CÓMIC
PUERTORRIQUEÑO
Pepito es un cómic sobre la familia puertorriqueña y una variedad de temas como la política y los problemas sociales de Puerto Rico.
INTERPRETIVE READING Read the text and answer the questions.
Los personajes
PEPITO , UN CÓMIC PUERTORRIQUEÑO
Pepito es un muchacho curioso de siete años. Vive con su mamá, su papá y su abuela. Tiene dos mascotas, Chupi y Thomas. Le gustan mucho los mantecados1 favorito es Daddy Yankee.
Pepito es un cómic sobre la familia puertorriqueña y una variedad de temas como la política y los problemas sociales de Puerto Rico.
Los personajes Pepito es un muchacho curioso de siete años.
Mamá es el pilar de la casa y papá usualmente es la víctima de los problemas del país. Tata es la abuela de Pepito y mamá de su mamá. Es una mujer fuerte.
Vive con su mamá, su papá y su abuela.
Tiene dos mascotas, Chupi y Thomas. Le gustan mucho los mantecados y su artista favorito es Daddy Yankee.
Mofin es un amigo de Pepito. Le gustan mucho la tecnología y la piña2 Yelitza es una amiga de Pepito. Es una niña muy inteligente y su interés principal es el rol de las mujeres en la sociedad. ice cream 2 pineapple
Mamá es el pilar de la casa y papá usualmente es la víctima de los problemas del país. Tata es la abuela de Pepito y mamá de su mamá. Es una mujer fuerte.
Mofin es un amigo de Pepito. Le gustan mucho la tecnología y la piña
1. ¿Cuántos años tiene Pepito?
2. ¿Cuántas personas viven con Pepito?
Yelitza es una amiga de Pepito. Es una niña muy inteligente y su interés principal es el rol de las mujeres en la sociedad. 1 ice cream 2 pineapple
3. ¿Quiénes son Chupi y Thomas?
4. ¿Qué estilo de música le gusta a Pepito?
5. ¿Cómo es su abuela?
6. ¿Qué le gusta a su amigo Mofin?
7. ¿Quién es Yelitza?
Pepito Cómics, Harold Jessurun y Aníbal Quiñones
1. ¿Cuántos años tiene Pepito?
2. ¿Cuántas personas viven con Pepito?
3. ¿Quiénes son Chupi y Thomas?
4. ¿Qué estilo de música le gusta a Pepito?
5. ¿Cómo es su abuela?
6. ¿Qué le gusta a su amigo Mofin?
7. ¿Quién es Yelitza? ¿Cómo es?
viven?


GRAMÁTICA pp. 92-94 VOCABULARIO pp. 96-98, 116




Nuestras culturas
An oral and a written activity designed to make a cultural comparison.

• Student Edition (print + digital)
• Workbook (print + digital)
• Performance tasks & unit projects
• 'My Progress' worksheets and rubrics
• Self-check quizzes
• Interactive activities in The KWL Hub
• Annotated Teacher’s Edition (print + digital)
• Assessment Pack with rubrics & alternatives
• Differentiation worksheets
• Heritage learner worksheets
• CTE Supplement
• ADI Companion
• AI Companion Guide
• Lesson Plans
• The KWL Hub
• Interactive Textbook & eBook
• LEO AI conversation partner (Levels 1-2)
• Skills report
• Assignments & gradebook
• LMS integration
LEO gives students unlimited opportunities to practice Spanish through guided, level-appropriate interpersonal conversations aligned to your lessons.
3 Conversations tied to unit vocabulary, grammar, and functions
3 Personalized feedback
3 Fully integrated—no extra login
3 Safe, supportive space to develop confidence
• Full conversation transcripts
• Analytics by student & class
• Participation tracking
• Clear indicators of support needs



Request a demo by scanning the QR code.
LEO significantly increases exposure to interpersonal communication, a critical ACTFL skill area and a known gap in many WL classrooms.
Companion readings for deeper cultural exploration, interpretive practice, and literacy development.

Meet the REPORTEROS READERS Editor:
• Fully aligned to Reporteros Revised Edition Levels 1-3
• Contemporary, engaging stories written for real interpretive growth
• Extend vocabulary, reinforce grammar, and build cultural awareness
• Perfect for class libraries, independent reading, and small-group instruction
• Available in print + digital (Hub integration)
Diego Ojeda is a Spanish teacher, author, and editor specializing in AcquisitionDriven Instruction materials. His expertise brings practical, classroomtested insights into every resource he creates, designed to support language acquisition effectively and engagingly.








Our REPORTEROS program meets ESSA Tier 4 criteria, validated by a rigorous research analysis conducted by the Johns Hopkins University School of Education and based on a thorough review of our instructional materials.
We proudly offer a program built on a well-defined logic model that ensures quality and effectiveness in language education.
Read the complete report by scanning the QR code below!

Would you like to request a free sample? Please scan the code!

A proficiency-based Spanish program that empowers students to communicate confidently and engage with the richness of the Spanish-speaking world.
Proficiency Path: Novice Low to Intermediate High
Print + Digital | Available June 2026
Contact your Klett World Languages representative klettwl.com/find-your-rep